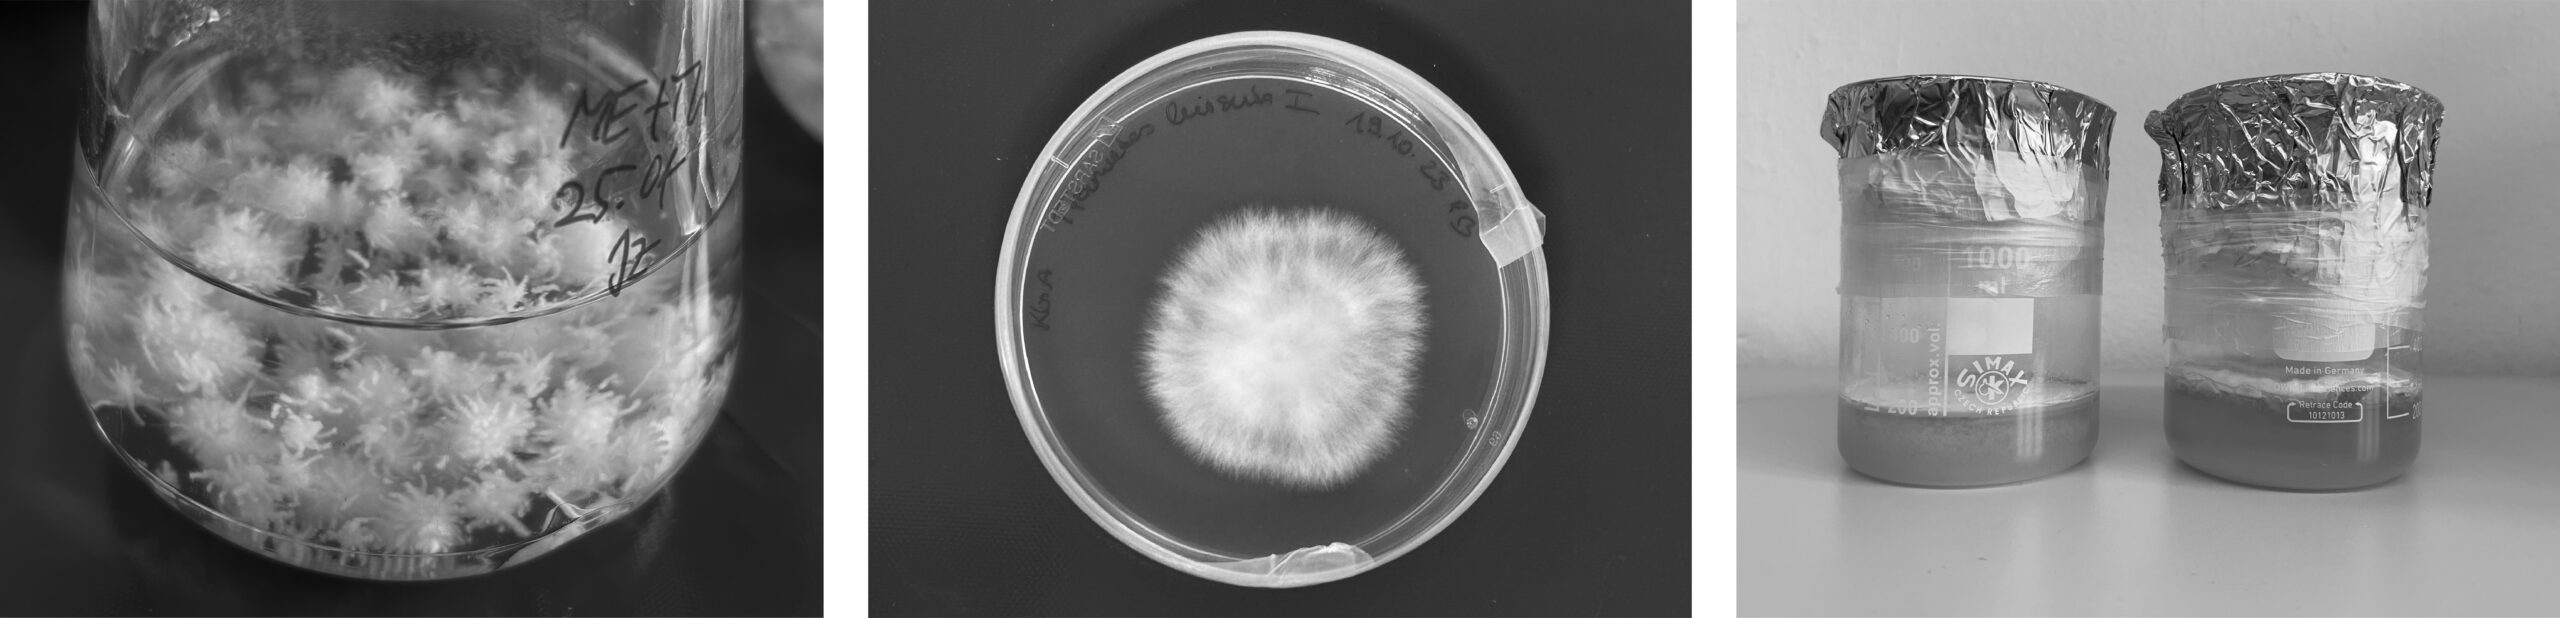

in collaboration with the Institute of Natural Materials Technology TU Dresden.
mycelium & fiber investigates the potential of fiber–mycelium composites as an alternative to conventional construction materials through design. conducted in collaboration with the institute of natural materials technology at tu dresden, the project comprises eight preliminary and six main experimental series. these explore a range of material combinations, with particular focus on silk–mycelium composites for their formability and aesthetic qualities.
the aim is to create a mycelium-based composite with improved properties to either pure mycelium or natural fibers alone.
preliminary experiments
the preliminary experiments test how fungal mycelium grows in combination with various natural fibers—silk, flax, cotton, and wool.
here, the focus lies on the aesthetic properties of those novel combinations: what is the dynamic of these synergies? does one material dominate, or do they exist in balance? where are the contrasts, and where are the similarities in these connections? and finally, do they physically reinforce each other?
on the right is a gallery showing specimens cultivated through different methods, using diverse woven materials, each producing unique results. all are combinations of trametes hirsuta and woven natural fibers.
research question: what forms, structures, and textures develop as mycelium integrates with woven natural fibers?

methods
three methods are used for cultivation: first, the mycelium of trametes hirsuta is grown on a malt–agar substrate; next, the biomass is used to produce a dynamic liquid culture; finally, the biomass is extracted to incubate the final static liquid culture.
the preliminary experiments test how fungal mycelium grows in combination with various natural fibers—silk, flax, cotton, and wool—before narrowing the focus to silk–mycelium composites for the main study.
shown below are the final two specimens from this phase. both combine woven silk and raw jute as a supporting material for trametes hirsuta to grow on. the thread is placed on the textile before sterilizing the materials, then incubated for 10 days. growth is more pronounced in areas with jute, and less so where only silk is present.




main experiments
the main study explores silk-mycelium composites and the nature of this novel material combination. what patterns emerge through mycelial growth? how do textile structures such as holes, layers, smocked silk, pleats, and three-dimensional draperies influence growth? does mycelium give silk structural stability and stiffness, and does silk enhance the tensile strength of pure mycelium?
six series of experiments track the growth of trametes hirsuta on manipulated woven silk samples using a static liquid cultivation method with malt extract medium. all samples have grown for fewer than 14 days.











selected specimens are curated for presentation in a metal frame. each is shown in a way that reflects its unique character. within the rigid grid, they reveal the lively and organic nature of their fabrication: a material half grown, half woven — a light, translucent filter that is soft like fungal mycelium, strong like a flexible composite, combining the strengths of both materials to achieve properties neither could provide alone.








The work offers a unique design perspective on a material that, as a future-oriented resource, opens new possibilities for design, architecture, and everyday applications while also challenging our notions of material aesthetics and durability. In addition to its visual qualities, the composite’s functional potentials—such as bonding, filtering, protecting, mediating, and damping—were explored and contextualized for future use.
© 2025 Judith Zbanek